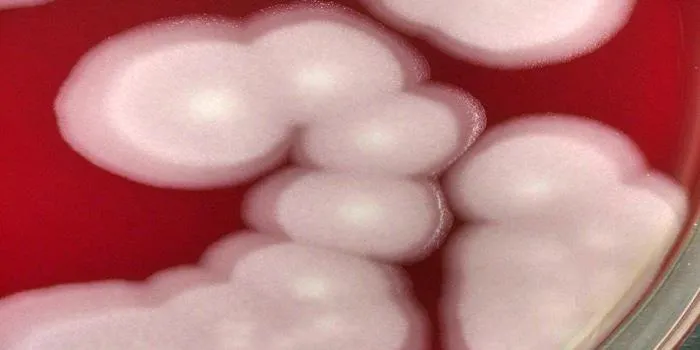
Pandoravirus: the melting Arctic is releasing ancient germs – how worried should we be?

Why Do Gray Hairs Have a Different Texture?
As people age, they often notice that their gray hair feels different from the rest of their strands. This change in texture can be attributed to several factors. Gray hair not only signifies a lack of pigmentation but also undergoes structural changes that affect its feel and appearance. The reason for these changes lies in the biology of hair and the natural aging process.
What is the new COVID-19 variant BA.2?
BA.2 is a subvariant of the Omicron strain of COVID-19, characterized by its increased transmissibility and potential to evade immunity from previous infections or vaccinations. It emerged as a concern for public health officials due to its rapid spread in various regions. In addition, "The Big Apple" is a well-known nickname for New York City, reflecting its vibrant culture and significance in the arts and finance. Various other cities have their own unique nicknames, often rooted in history or local features.
Pandoravirus: the melting Arctic is releasing ancient germs – how worried should we be?
As the Arctic ice melts due to climate change, ancient viruses like Pandoravirus are being released from permafrost, raising concerns about potential health risks. Scientists warn that while these viruses are mostly harmless to humans, the unknowns of ancient pathogens could pose threats to ecosystems and public health. In a different context, the nicknames of famous cities, such as "The Big Apple" for New York City, reveal intriguing stories and cultural significance, illustrating how identity and history shape urban life.
Could I have had COVID and not realised it?
In "Could I have had COVID and not realised it?", the discussion revolves around the possibility of experiencing asymptomatic COVID-19 infections, emphasizing the importance of awareness and testing. Meanwhile, "The Big Apple" explores the origins of this iconic nickname for New York City, delving into its cultural significance and historical context. The article also examines how eight other renowned cities acquired their unique monikers, revealing the stories and characteristics that define them and contribute to their identities.
If I am vaccinated and get COVID-19, what are my chances of dying? The answer is surprisingly hard to find
Exploring the complexities of COVID-19 vaccination reveals that while vaccines significantly reduce the risk of severe illness and death, breakthrough infections can still occur. Factors such as age, underlying health conditions, and the specific variant of the virus play crucial roles in determining outcomes. In a separate context, the nicknames of cities like New York, known as "The Big Apple," often stem from historical, cultural, or economic influences, showcasing how these identifiers reflect the unique characteristics of each location.
An excess of empathy can be bad for your mental health
Excessive empathy, while often viewed as a positive trait, can negatively impact mental health by leading to emotional exhaustion and burnout. Individuals who constantly prioritize others' feelings over their own may struggle with setting boundaries, resulting in increased stress and anxiety. In "The Big Apple" and other famous cities, nicknames often reflect historical, cultural, or social significance. These monikers encapsulate each city's unique identity, showcasing how place names can convey deeper meanings and connections to their respective histories and communities.
Dying for makeup: Lead cosmetics poisoned 18th-century European socialites
In 18th-century Europe, socialites were captivated by the allure of makeup, often unaware of the dangers posed by lead-based products. This obsession led to serious health issues, as the toxic ingredients caused severe poisoning and even death among some users. Meanwhile, cities around the world have earned their nicknames through various historical, cultural, or geographical influences. For instance, New York City is famously known as "The Big Apple," a moniker that reflects its vibrant energy and significance in American culture.
Guns, not roses – here’s the true story of penicillin’s first patient
The story of penicillin's first patient reveals a fascinating intersection of medical history and human resilience, highlighting the groundbreaking impact of antibiotics in treating infections. Meanwhile, the exploration of famous cities and their nicknames uncovers the cultural and historical significance behind names like "The Big Apple." Each nickname tells a unique tale, reflecting local pride, economic history, or notable events that shaped these urban landscapes, offering a glimpse into the identity of places that resonate globally.
Can churches be protectors of public health?
The role of churches in public health has evolved, with many congregations stepping up to provide essential services like food distribution, mental health support, and vaccination drives. Their community presence allows them to reach vulnerable populations effectively. In "The Big Apple," along with eight other cities, the origins of famous nicknames reveal cultural, historical, or geographical significance. These monikers often reflect local identity and contribute to the cities' charm, offering insights into their unique characteristics and stories.
Why daylight saving time is unhealthy – a neurologist explains
Daylight saving time can disrupt circadian rhythms, leading to sleep disturbances and increased health risks, according to a neurologist. The shift in time can affect mood, cognitive function, and overall well-being, making it a controversial practice. In another context, "The Big Apple" refers to New York City, a nickname that evokes its vibrant culture and significance in the jazz scene. Similarly, other famous cities have unique nicknames that reflect their history, characteristics, or cultural identity.
Wastewater monitoring took off during the COVID-19 pandemic – and here’s how it could help head off future outbreaks
During the COVID-19 pandemic, wastewater monitoring emerged as a crucial tool for tracking viral outbreaks, providing early warning signs of infection trends in communities. This surveillance method analyzes sewage for traces of pathogens, allowing health officials to respond proactively to potential surges in cases. Meanwhile, the nicknames of cities like New York, known as "The Big Apple," often reflect their cultural, historical, or economic significance. Exploring these monikers reveals fascinating insights into the identities and stories of these urban centers.
Yes, the ‘terrible twos’ are full-on – but let’s look at things from a child’s perspective
The ‘terrible twos’ can be overwhelming for parents, but understanding this stage from a child's perspective reveals their need for independence and exploration. As they navigate emotions and boundaries, toddlers are simply trying to express themselves in a world that feels both exciting and intimidating. Meanwhile, cities like New York, known as "The Big Apple," have fascinating stories behind their nicknames, reflecting their unique characteristics and cultural significance. Exploring these narratives adds depth to our appreciation of both childhood development and urban identity.
Pandemic decision-making is difficult and exhausting – here’s the psychology that explains why
Pandemic decision-making poses significant challenges due to the overwhelming uncertainty and rapidly changing information. The psychological burden stems from fear, stress, and the pressure to make choices that impact public health. This complexity can lead to decision fatigue, where individuals struggle to process information and weigh options effectively. Meanwhile, exploring the origins of famous city nicknames reveals cultural and historical narratives, illustrating how names like "The Big Apple" reflect unique identities and stories behind each urban center.
Brains are bad at big numbers, making it impossible to grasp what a million COVID-19 deaths really means
Humans often struggle to comprehend large numbers, which can lead to a disconnect when faced with staggering statistics like a million COVID-19 deaths. Such figures become abstract, overshadowing the individual lives lost and the impact on families and communities. Similarly, the nicknames of famous cities, such as "The Big Apple," often reflect cultural, historical, or geographical influences, each carrying its own unique story that adds depth to our understanding of these urban centers.
Just how accurate are rapid antigen tests? Two testing experts explain the latest data
Rapid antigen tests are a quick way to detect infections, but their accuracy can vary based on factors like timing and viral load. Experts emphasize that while these tests can provide timely results, they may miss some cases, particularly in asymptomatic individuals. Meanwhile, cities around the world have unique nicknames that often reflect their history, culture, or notable characteristics. For instance, New York City is famously known as "The Big Apple," a name that has intriguing origins tied to its vibrant jazz scene and agricultural roots.
Baby formula industry was primed for disaster long before key factory closed down
The baby formula industry faced significant vulnerabilities prior to the closure of a major manufacturing facility, highlighting systemic issues in supply chains, regulatory oversight, and market dependency. This crisis underscored the fragility of food production systems, leading to severe shortages and public concern. Meanwhile, the exploration of famous cities and their nicknames reveals the historical and cultural significance behind these monikers, reflecting unique characteristics and local legends that shape their identities, contributing to their global recognition.
Haven’t had COVID yet? It could be more than just luck
Recent studies suggest that not contracting COVID-19 may be linked to factors beyond mere luck, such as genetic predispositions or immune responses. Meanwhile, cities around the world have fascinating origins for their nicknames. For instance, New York City, known as "The Big Apple," reflects its vibrant cultural and economic significance. Similarly, other famous cities have unique stories behind their monikers, showcasing their history, geography, and the characteristics that have defined them over time.
Why stress-related illness is so hard to diagnose, and how a patient-centred playful approach can help
Stress-related illnesses often present with vague and overlapping symptoms, making them difficult to diagnose. Conventional medical approaches may overlook the emotional and psychological components of these conditions. A patient-centered, playful approach can foster open communication and trust, enabling healthcare providers to understand patients’ experiences more deeply. This method encourages a supportive environment, allowing individuals to express their concerns more freely, ultimately leading to more accurate diagnoses and effective treatment plans. Exploring the history behind famous city nicknames adds a cultural layer to this discussion.
When texts suddenly stop: Why people ghost on social media
When texts suddenly stop, it often leads to feelings of confusion and frustration, especially on social media platforms where communication is expected to be more immediate. Ghosting can stem from various reasons, including anxiety, avoidance of confrontation, or simply losing interest. Meanwhile, exploring the origins of city nicknames like "The Big Apple" reveals fascinating stories behind their identities. Each nickname often reflects historical, cultural, or geographical significance, showcasing the unique characteristics that define these famous urban centers.
What’s in a name? Why giving monkeypox a new one is a good idea
The discussion around renaming monkeypox highlights the importance of language in shaping public perception and stigma. A new name could reduce fear, promote understanding, and encourage vaccination. Similarly, the nicknames of famous cities often reflect their unique characteristics or historical significance, enhancing cultural identity and tourism. For instance, "The Big Apple" signifies New York's vibrant allure, while other cities have earned their monikers through local legends or distinctive features, contributing to their charm and recognition worldwide.